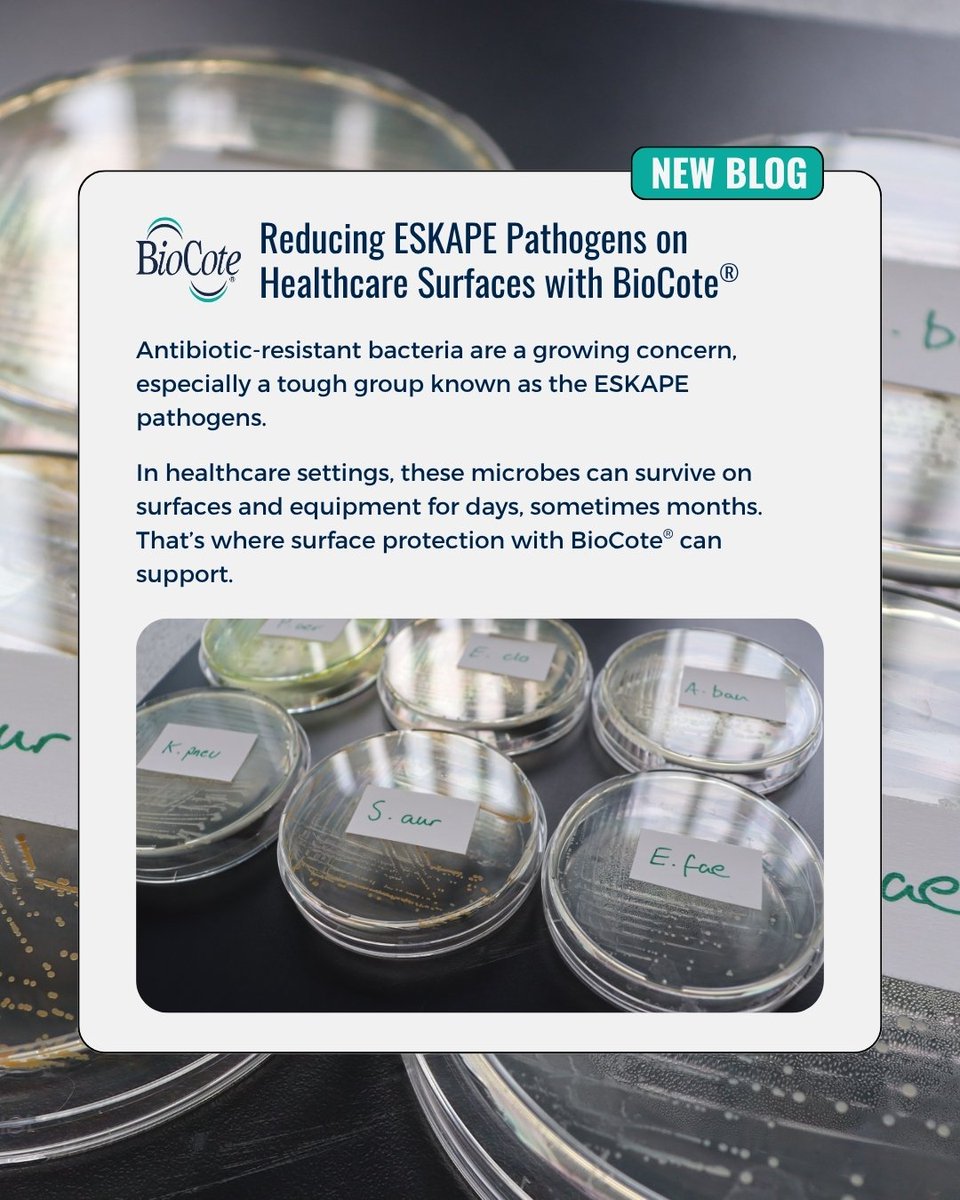

BioCote®
@biocote
Delivering integrated #antimicrobial solutions since 1994, BioCote® is a trusted partner for leading brands, manufacturers and product innovators worldwide.
ID: 132131870
http://www.biocote.com 12-04-2010 10:59:20
3,3K Tweet
937 Takipçi
482 Takip Edilen





It’s #TakeYourDogToWorkDay – and even their toys can benefit from BioCote® antimicrobial technology. 🐾 Rosewood Pet creates dog toys that reduce microbial growth up to 99.9%, helping them stay fresher for longer! 🔗 eu1.hubs.ly/H0kl5j30 #PetProducts #DogToys #Sustainable










Invisible, but always working. BioCote® is built into products like Matchstick Monkey baby teethers,without changing how they look or feel. It reduces up to 99.9% of bacteria 24/7! 🔗 eu1.hubs.ly/H0ly3sQ0 #BabyProducts #HACCPApproved #TeethingToys #DesignResponsibly #BioCote






Our friends at Mediclinics Inter. just published a blog on how BioCote® keeps washrooms cleaner for longer 💡 From hand dryers to baby changing stations, hygiene is built in. 🔗 eu1.hubs.ly/H0lMppK0 #BioCotePartners #Mediclinics #AntimicrobialTechnology #Hygiene #BuiltIn